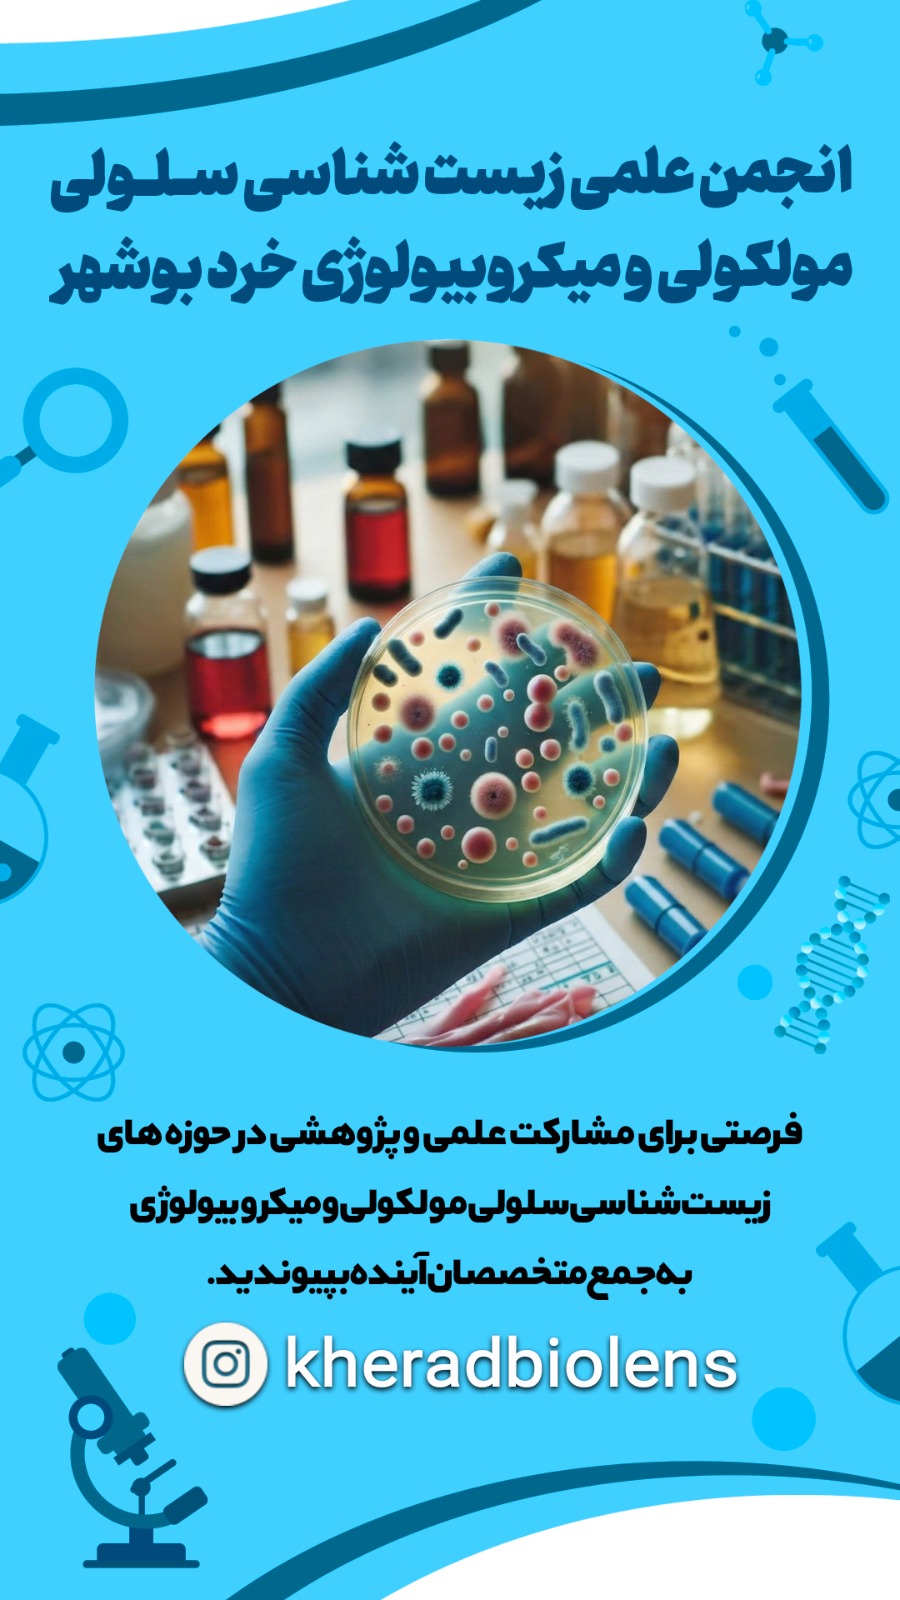
دوره فوقجامع سرطان یک برنامه آموزشی 160ساعته دوره فوقجامع سرطان یک برنامه آموزشی 160ساعته

کد تخفیف اختصاصی انجمن شما:
cancern402
💢 اتحاد زیستشناسان ایران (آکادمی سرطان ایران) با همکاری برترین مراکز تحقیقاتی و درمانی کشور برگزار میکند:
🎓 دوره (فوق) جامع سرطان
۸۰ جلسه و بیش ۱۶۰ ساعت آموزش
۷ دوره تخصصی در یک دوره:
1️⃣ زیستشناسی سلولی و مولکولی سرطان
2️⃣ روشهای تشخیص و مدلسازی آزمایشگاهی
3️⃣ بیوانفورماتیک و هوش مصنوعی در سرطان
4️⃣ درمانهای رایج و نوین
5️⃣ تجاریسازی و اصول رگولاتوری
6️⃣ ژنتیک و اپیژنتیک سرطان
7️⃣ مبانی ایمونولوژی و عوامل ایجادکننده سرطان
✨ ویژگیهای دوره:
✅ کارآموزی رایگان برای بیش از ۸۰ نفر در مراکز معتبر بالینی و صنعتی
✅ دسترسی مادامالعمر به ویدیوها و جزوات تایپشده
✅ دریافت گواهی معتبر و مشترک از اتحاد زیستشناسان ایران، مرکز تحقیقات بیولوژی انستیتو کنسر و مرکز طبی کودکان بیمارستان امام خمینی
✅ جامعترین سرفصلهای آموزشی با کمترین هزینه ممکن
👨⚕️ رئیس دوره: پروفسور امیرعلی حمیدیه
📅 شروع: شنبه ۱۷ آبان ۱۴۰۴
⚠️ ظرفیت بسیار محدود
📩 برای دریافت اطلاعات بیشتر، کلمهی «سرطان» را در گروه اتحاد زیستشناسان ایران کامنت کنید.

🔰دوره فوقجامع سرطان یک برنامه آموزشی 160ساعته است که با همکاری مراکز زیر برگزار میشود:
🔸اتحاد زیستشناسان ایران (آکادمی سرطان ایران)
🔸مرکز طبی کودکان بیمارستان امام خمینی
🔸انستیتو کنسر بیمارستان امام خمینی
🔸مرکز نوآوری کوبل
✅ این دوره شامل ۱۴ سرفصل:
۱) اپیدمیولوژی و نگاه بالینی به سرطان
۲و۳)مفاهیم پایه و بیولوژی سرطان
۴) متاستاز و ریزمحیط تومور
۵) عوامل ایجادکننده سرطان
۶) اپیژنتیک سرطان
۷) روشهای آزمایشگاهی و مدلسازی تومورها
۸) روشهای تشخیص سرطان
۹) ژنومیک و بیوانفورماتیک سرطان
۱۰) هوش مصنوعی در سرطان
۱۱) درمانهای سرطان (کلاسیک و نوین)
۱۲) کارآفرینی و تجاریسازی در سرطان
۱۳) رگولاتوری در حوزه سرطان
۱۴) جمعبندی و آینده پژوهش سرطان
🌟ویژگیهای متمایز دوره:
۱. جامعترینسرفصلهای آموزشی این مجموعه از ۷ دورهی مستقل ولی همافزا تشکیل شدهاست.
۲. تدریس توسط برجستهترین اساتید و متخصصان آکادمیک و صنعت درمان سرطان کشور
۳. بیش از 160 ساعت محتوای تخصصی در ۸۰ جلسه
۴. فرصت کارآموزی رایگان
🔸۳۰ نفر در مرکز نوآوری کوبل
🔸۷۰ نفر در مرکز طبی کودکان (یک ماه)
۵. گواهی معتبر مشترک از طرف اتحاد زیستشناسان ایران و انستیتو کنسر بیمارستان امام خمینی
۶. دسترسی مادامالعمربه محتوای دوره (ویدیوها و جزوات کامل).
♻️ هدف این دوره: توانمندسازی شرکتکنندگان برای ورود به پژوهش و کارآفرینی در حوزه سرطان، تقویت رزومهی علمی و فراهمسازی مسیرهای همکاری و اشتغال در مراکز تحقیقاتی و صنعت
اگر شرکتکننده دورههای جامع قبلی اتحاد هستید یا تمایل به ثبت نام گروهی دارید به ادمین بگید تا کد تخفیف وفاداری و گروهی برای شما ارسال کنند
🌐لینک ثبتنام:
https://biologyevents.ir/course/830


